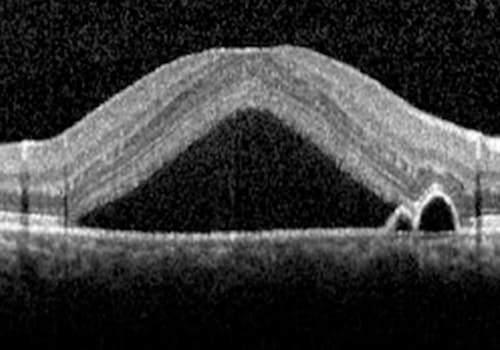

O que é retinopatia Serosa Central?
A Retinopatia Serosa Central, ou corioretinopatia serosa central, é uma doença inflamatória mais comum em homens, entre 20-40 anos de idade. Ela é caracterizada pela presença de fluído sub-retiniano e por descolamento da retina neurossensorial.
A causa exata da corioretinopatia serosa central não é totalmente compreendida, mas acredita-se que fatores como estresse, hormônios, história familiar e uso de certos medicamentos, como corticosteroides, possam estar envolvidos no seu desenvolvimento.
Quais são os sintomas?
•Visão borrada ou distorcida,
•Manchas escuras na visão central
•Diminuição da acuidade visual
Como é realizado do diagnóstico?
Com exames realizados por oftalmologista especialista em retina, incluindo:
•Mapeamento de retina (fundo de olho)
•Retinografia colorida
•Tomografia de coerência óptica (OCT)
Qual o tratamento?
•Observação nos casos inicias (até 3-4 meses)
•Fotocoagulação com laser convencional
•Laser micropulso amarelo ou vermelho
•Terapia fotodinâmica com Visudyne (PDT)







